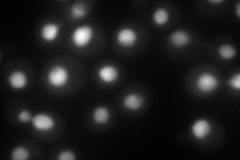
YPL125W
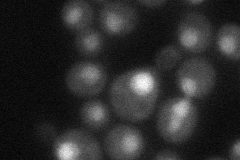
YPL125W
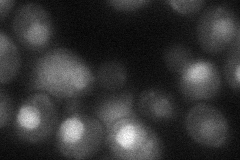
YPL125W
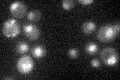
YPL125W

View description
Karyopherin responsible for the nuclear import of ribosome maturation factor Rfp1p
Localization:
Intensity:
Fold change:
Significance:
-
C’ GFP library in SD

nucleus27.43 -
N' NOP1pr-GFP in SD

nucleus99.2197 -
N' TEF2pr-mCherry in SD
nucleus101.513 -
N' NATIVEpr-GFP in SD
nucleus46.5925 -
N' TEF2pr-VC and Cyto-VN in SD
nucleus42.1775 -
C’ GFP library in SD+DTT

nucleus26.980.98No -
C’ GFP library in SD+H2O2

nucleus29.191.06No -
C’ GFP library in Starvation Media
nucleus32.261.17No -
C’ GFP library on the background of Pup2-DaMP

nucleus -
C’ GFP library on the background of CCT mutant

nucleus27.08040.98689No
